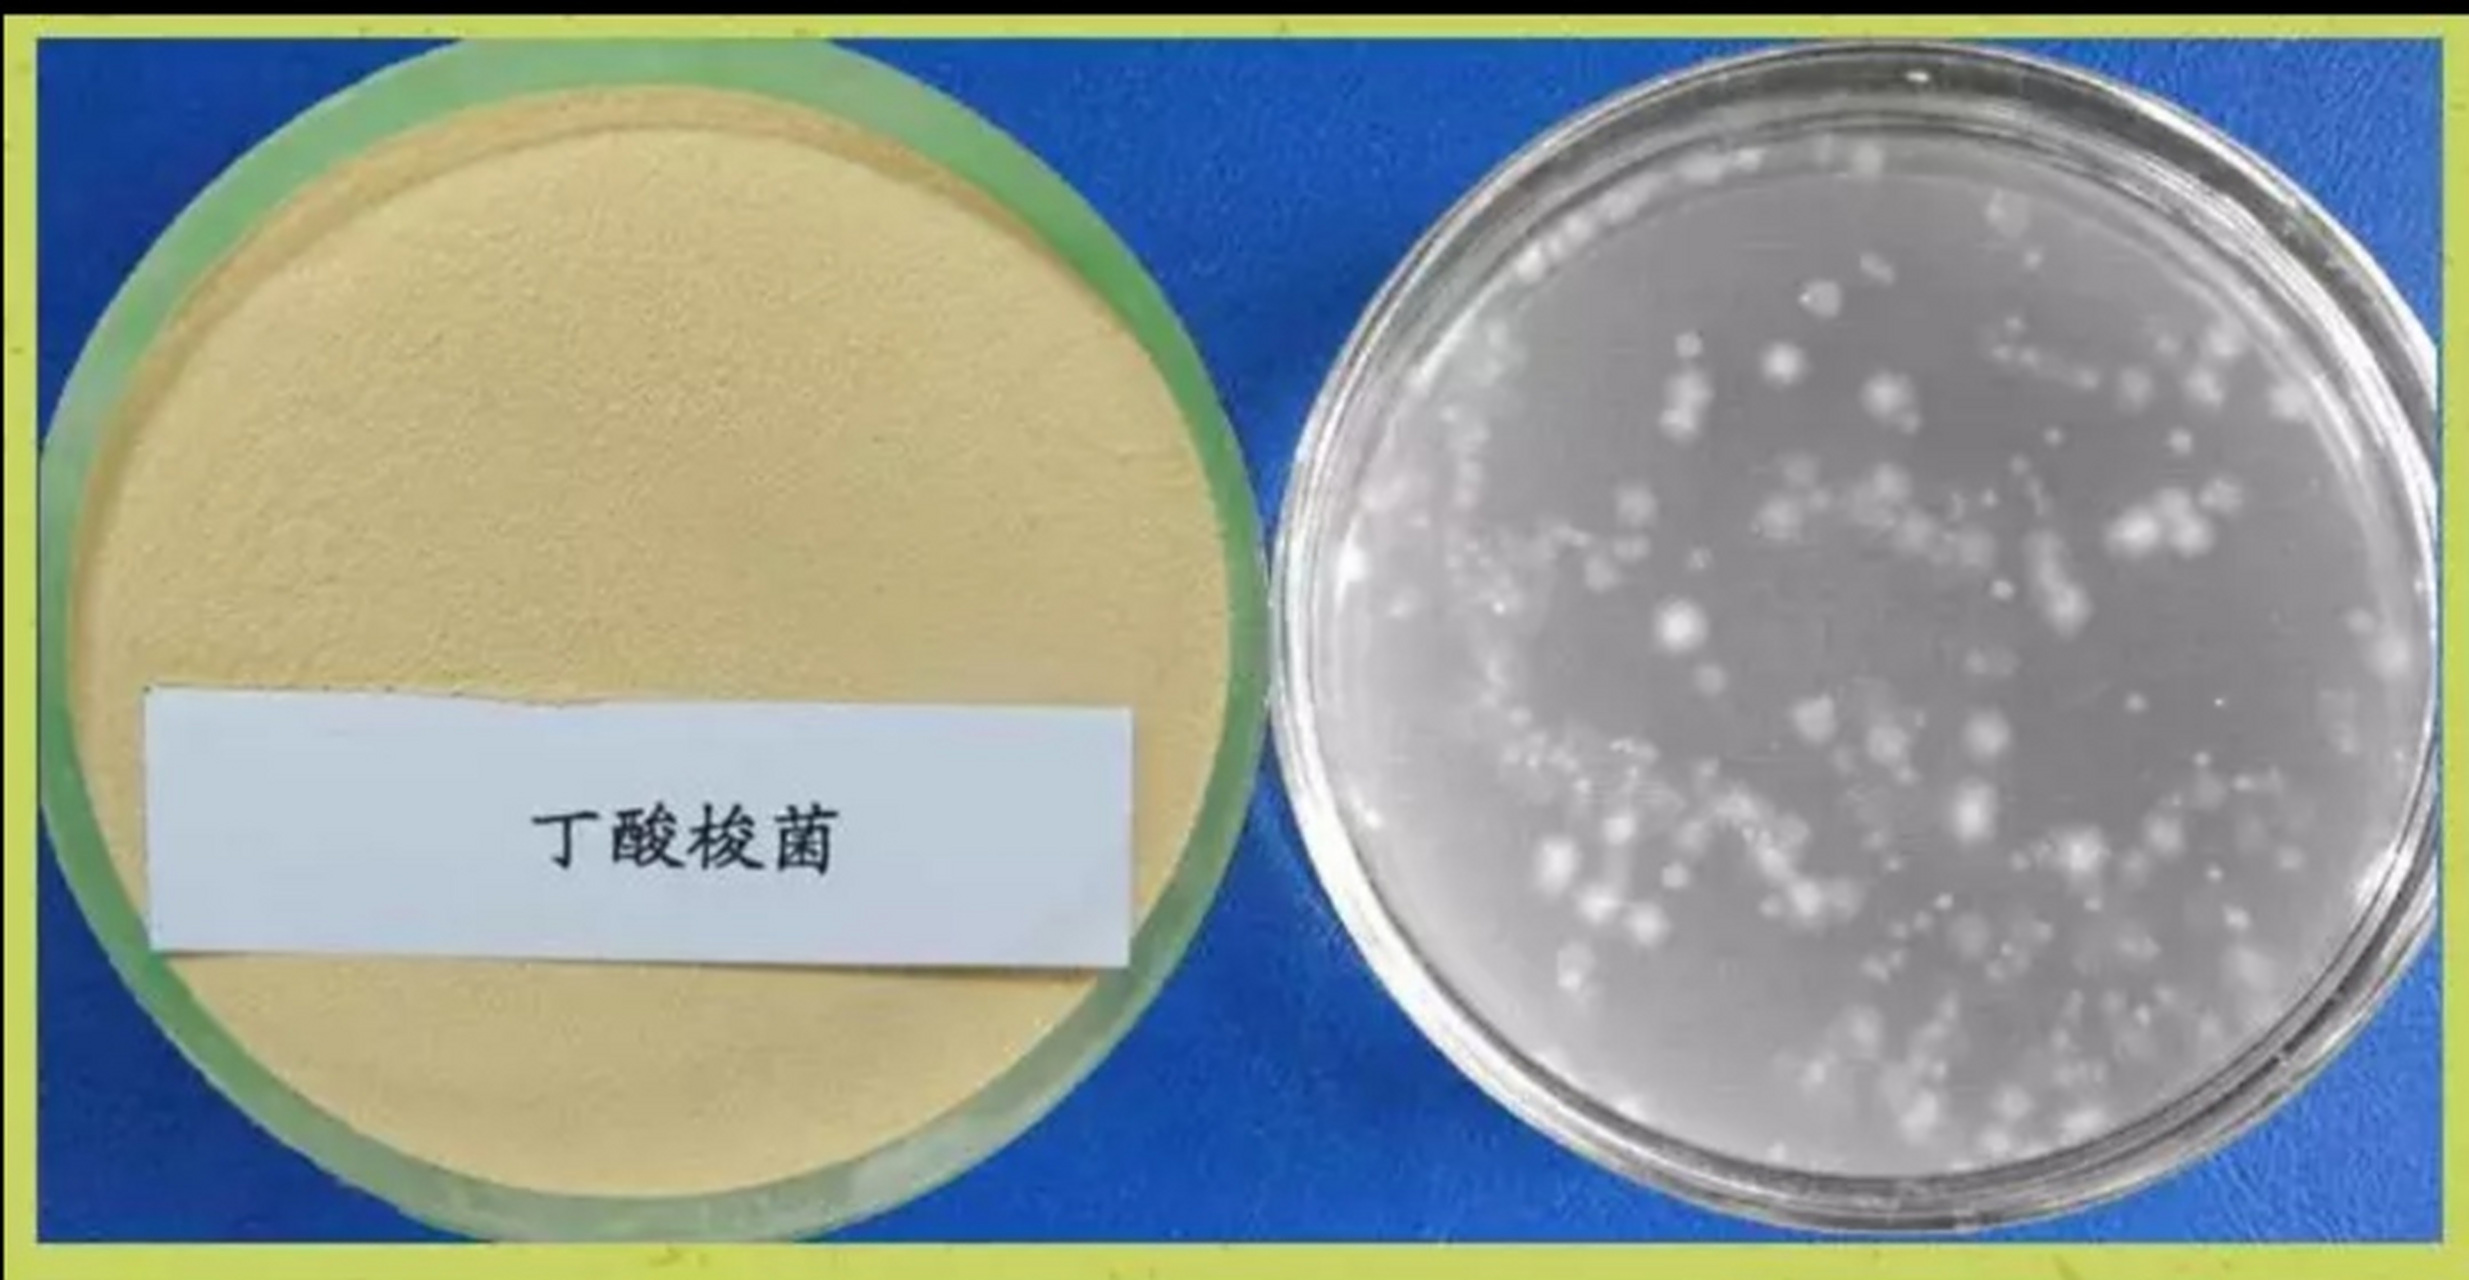
1,丁酸梭菌是1933年一个日本宫入近治博士发现的并报告的,名为革兰氏

洛酸菌

干酪乳杆菌
图片尺寸1280x1280
益生菌和乳酸菌的区别有那些
图片尺寸500x295
常乐康二联活菌
图片尺寸300x300
火锅标配73康师傅小酪多多乳酸菌
图片尺寸1080x1439
求求都去喝60这乳酸菌我每天当水喝
图片尺寸1080x1440
丁酸梭菌又名酪酸菌,是我国农业部于2009年7月批准的新一代微生物饲料
图片尺寸499x354
醋酸菌
图片尺寸1200x857
1,丁酸梭菌是1933年一个日本宫入近治博士发现的并报告的,名为革兰氏
图片尺寸2469x1280
丁酸梭菌酪酸菌添加拌料改善肠道预防弧菌白便空肠空胃腹泻白痢
图片尺寸800x800
益可劲副干酪乳杆菌
图片尺寸474x265
副干酪乳杆菌mp137
图片尺寸658x386
这是什么菌(用来做酸奶的)
图片尺寸1280x960
康师傅小酪多多乳酸菌饮品330ml15瓶脂肪脂肪酸酸奶含乳饮料
图片尺寸800x800
日本酪酸菌整肠剂
图片尺寸1080x1440
牛奶有相似之处,都是通过发酵过程来制作的,也都含有可以保健的乳酸菌
图片尺寸640x427
她说nicorio益生菌,这个效果不是嘎嘎快的那种,属于慢养生,慢慢调节的
图片尺寸1080x1439
显微镜下的乳酸菌
图片尺寸591x447
阿泰宁 酪酸梭菌活菌胶囊 0.
图片尺寸380x380
太难买了日本酪酸菌整肠剂调节肠道菌群
图片尺寸1080x1440
爱蒙塔尔奶酪是瑞士的一种上乘奶酪,表层有许多奶酪
图片尺寸717x1112